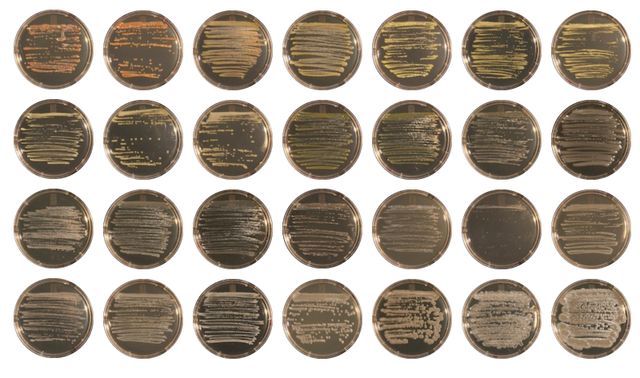
'Bacterial Encounters'

[Correction: Several event dates for the Art|Sci Center have been changed. Please see below for updated dates.]
The UCLA Department of Design | Media Arts (DMA) is offering a variety of events for the public's enjoyment this spring, including exhibitions and lectures.
For events at the UCLA Broad Art Center's New Wight Gallery (Room 1100), EDA facility (Room 1250) or Game Lab (Room 3252), all-day parking ($11) and short-term parking (payable at pay stations) are available in Lot 3 (enter campus at Hilgard Avenue and Wyton Drive).
All-day parking ($11) for events at the California NanoSystems Institute is available in Lot 9 (enter campus at the intersection of Hilgard and Manning avenues or Hilgard and Le Conte avenues, or at the intersection of Westwood and Wilshire boulevards).
Visit www.dma.ucla.edu for live streaming coverage of lectures. Programs are subject to change. For updated information, gallery hours and confirmation of events, call 310-825-9007 or visit www.dma.ucla.edu.
FREE EXHIBITION
May 16–30
Design | Media Arts M.F.A Graduate Exhibition
Opening reception: Thursday, May 16, 5 p.m.
New Wight Gallery (1100), Broad Art Center
This group exhibition features works by UCLA Design | Media Arts M.F.A. graduate students, including Gottfried Haider, Nicholas Hanna, Phoebe Hui, Kian Peng (Ben) Ong, Christopher Reilly, Dennis Rosenfeld and Richard Wheeler.
June 6–15
2013 Design | Media Arts Senior Exhibition
Opening reception: Thursday, June 6, 5–8 p.m.
EDA (Room 1250), Broad Art Center
This exhibition, featuring the work of graduating seniors from UCLA Design | Media Arts, represents the culmination of a broad and cohesive curriculum in print, form, programming, video and sound.
FREE LECTURES & EVENTS
Tuesday, April 23
6 p.m.
Design | Media Arts Lecture
Jim Campbell
EDA (Room 1250), Broad Art Center
Campbell is a contemporary San Francisco–based artist who primarily works with LED light installations.
ART|SCI CENTER LECTURES, EXHIBITIONS & EVENTS
For updated information on Art|Sci programs, please visit http://artsci.ucla.edu.
New date: Thursday, April 4 (originally listed as Thursday, March 28)
5–7 p.m.
Art|Sci Exhibition + North | South Mixer
James Gimzewski — 'Duality'
Art | Sci Gallery and Presentation Space, California NanoSystems Institute (CNSI)
Gimzewski is a UCLA professor of chemistry and biochemistry and a researcher for the California NanoSystems Institute at UCLA.
New date: Thursday, April 18 (originally listed as Thursday, April 11)
5–7 p.m.Art|Sci Exhibition + Workshop
Christina Agapakis — 'Bacterial Encounters'
Art | Sci Gallery, California NanoSystems Institute (CNSI)
Microbes are often synonymous with rot, decay, infection and disease. When microbes are made visible — or worse, odorous — it signals danger, a situation best avoided. But microbes are unavoidable, essential as part of the ecology of the healthy human body and the global dynamics of biogeochemical cycles. The growing realization of microbial usefulness and diversity is changing our relationship to microorganisms from one of fear, isolation and sterilization to a more ecological understanding of symbiotic exchange. "Bacterial Encounters" is an exploration of nature and culture from a microbiological perspective, capturing the microbial ecology of the human body and the living diversity thriving after the death of the Salton Sea. Through culturing such microbes, we make visible the ecologies that make up our bodies and our world.
Thursday, April 18
7–9 p.m.
Art|Sci North | South Mixer
UCLA Leonardo Art Science Evening Rendezvous (LASER) — 'Speaking Your Mind'
Presentation Space, California NanoSystems Institute (CNSI)
The Art | Sci Institute hosts artists, scientists and humanists who will present works that cross art–science boundaries.
Thursday, April 25
5–7 p.m.
Art|Sci Exhibition
Megan Daalder — 'Project Eureka'
Art|Sci Gallery, California NanoSystems Institute (CNSI)
"Project Eureka" is a shape-shifting narrative that will unfold over the course of 2013. Through performance, installation and video, the project will follow the first and last "designer baby," as she struggles to contribute to the future of humanity in a post–climate change world.
Thursday, May 9
7–9 p.m.
Art|Sci North | South Mixer
UCLA Leonardo Art Science Evening Rendezvous (LASER) — 'Space and Place'
(Check http://artsci.ucla.edu for location.)
The Art | Sci Institute hosts artists, scientists and humanists to present their work that crosses the art/science boundaries.
Thursday, May 30
5–7 p.m.
Art|Sci Exhibition Opening
David Familian — 'Echo and Narcissus'
Art|Sci Gallery, California NanoSystems Institute (CNSI)
"Echo and Narcissus" is an installation that explores the ancient myth from Ovid's "Metamorphoses" as a metaphor for the interaction between two individuals who cannot communicate with one another. The installation consists of an interactive visual projection on water, a soundtrack of Echo's voice and projected text generated from a script, and each of these distinct elements utilizes counterpoint to produce a series of visual and sonic relationships. A viewer will look into the water to see an image of their own face gradually materializing, dematerializing, disappearing, then reappearing once again in different forms. As the counterpoint, Echo's voice permeates the space, moving throughout the gallery, creating a haunting affect as it surrounds the viewer, then recedes. A text projected along the wall generates a narrative that is in dialogue with Echo's voice.
UCLA GAME LAB LECTURES & EVENTS
Game Lab programs are held in the UCLA Game Lab at the Broad Art Center (Room 3252) unless otherwise noted. For updated information, please visit http://games.ucla.edu/.
Monday, April 8
5:30 p.m.
UCLA Game Lab Lecture
Joseph Delappe
UCLA Game Lab (Room 3252), Broad Art Center
Delappe is a professor in the department of art at the University of Nevada, where he directs the digital media program. Working with electronic and new media since 1983, his work in online gaming performance and electromechanical installation has been shown throughout the United States and abroad.
Thursday, April 11
5:30 p.m.
Introduction to Augmented Reality
UCLA Game Lab (Room 3252), Broad Art Center
Meet with engineers from Daqri (www.daqri.com) and learn about the current state of the art in the field of augmented reality.
Wednesday, May 8
7 p.m.
UCLA Game Art Festival
Hammer Museum
In partnership with the Hammer Student Association, UCLA Game Lab presents an evening of innovative gaming, curated by Game Lab director and associate professor of design and media arts Eddo Stern. With games ranging from the bombastic and performative to the intimate and personal, these ambitious and participatory projects use a variety of media and modes of expression. Browse the games or participate in a tournament while enjoying live music, refreshments and game-inspired artwork.
For more news, visit the UCLA Newsroom and follow us on Twitter.